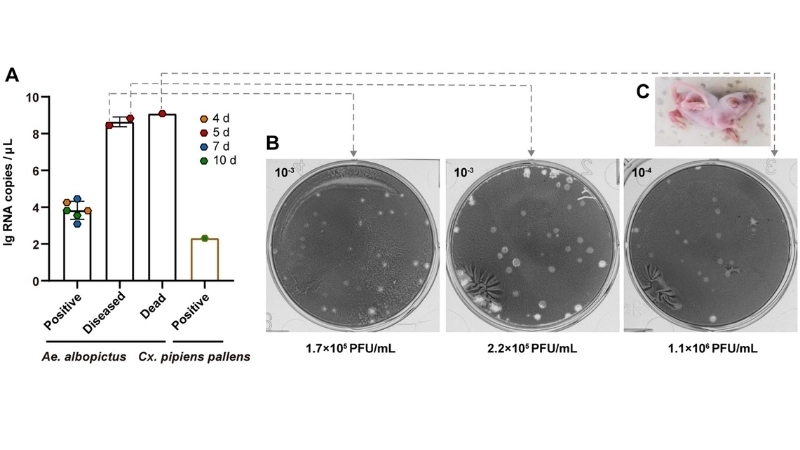
Tahyna Virus Infection under Tahyna virus research

Tahyna Virus Infection is a mosquito-borne illness affecting humans in certain regions. Early recognition of symptoms and proper precautions can prevent serious complications.
What are the main causes of Tahyna Virus Infection?
- Tahyna Virus Infection is primarily transmitted through mosquito bites, particularly from species active during warm seasons in endemic regions.
- Exposure to forested or rural areas increases the risk of contracting Tahyna Virus Infection due to high mosquito activity.
- Inadequate use of insect repellents and protective clothing can lead to higher susceptibility to Tahyna Virus Infection.
Key symptoms of Tahyna Virus Infection to watch for
- Individuals with Tahyna Virus Infection may experience fever, headaches, and muscle aches within a few days of exposure.
- Rash, fatigue, and mild joint pain are common indicators signaling the onset of Tahyna Virus Infection.
- Gastrointestinal discomfort and mild flu-like symptoms often accompany early stages of Tahyna Virus Infection.

>>>Click to see more: Understanding semliki forest virus disease causes and risks
How can you prevent Tahyna Virus Infection effectively?
- Apply insect repellents and wear long-sleeved clothing to reduce the likelihood of mosquito bites in high-risk areas.
- Use window screens, bed nets, and other protective barriers to minimize direct contact with mosquitos carrying Tahyna Virus Infection.
- Avoid outdoor activities during peak mosquito activity times, such as dawn and dusk, to lower the risk of contracting the virus.
>>>Click to see more: Everything you need to know about O'nyong'nyong Fever
Image description of Tahyna Virus Infection
Tahyna Virus Infection is a mosquito-borne viral illness that causes mild flu-like symptoms, rashes, and joint pain. While rarely severe, it can affect anyone exposed in endemic regions.

>>>Click to see more: Understanding lujo hemorrhagic fever symptoms early
Understanding Tahyna Virus Infection is essential for prevention and safety. Stay informed, follow public health guidance, and reduce exposure to infected mosquitoes.





